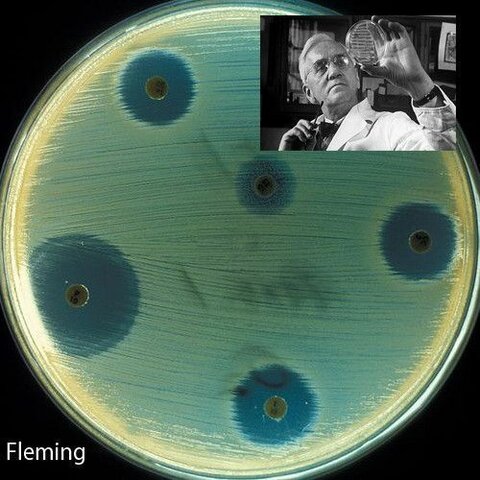
1920

-
 Epidemia de cólera
Epidemia de cólera -
Se crea el Consejo superior de salubridad
-
 Se destacó una rama de instituciones para el cuidado de la salud
Se destacó una rama de instituciones para el cuidado de la salud -
 En el parámetro inglés fue aprobada una ley de salud pública creando una dirección general de salud
En el parámetro inglés fue aprobada una ley de salud pública creando una dirección general de salud -
 Primera conferencia sanitaria internacional
Primera conferencia sanitaria internacional -
 Nace la primera vacuna para el cólera
Nace la primera vacuna para el cólera -
Se celebro el congreso higiénico pedagógico en el cual se abordaron temas con la salud
-
 Se funda el instituto médico nacional
Se funda el instituto médico nacional -
 Se funda el instituto geológico
Se funda el instituto geológico -
 Físico alemán Wilhelm Conrad R. descubre los rayos X
Físico alemán Wilhelm Conrad R. descubre los rayos X -
El médico Eduardo Liceaga presidente del consejo superior de salud construye el hospital general
-
 Se crea Instituto Nacional de salud pública (INSP)
Se crea Instituto Nacional de salud pública (INSP) -
Félix Hoffmann desarrolla la aspirina
-
 Nace la OPS debido a las epidemias que afectaban a la población y al país en la economía
Nace la OPS debido a las epidemias que afectaban a la población y al país en la economía -
Nace la oficina internacional de higiene pública OHP responsable de enfermedades epidémica
-
 Epidemia de influencia por falta de recursos e higiene
Epidemia de influencia por falta de recursos e higiene -
Alexander Fleming descubre un hongo llamado "penicillum"
-
 Emisión del código sanitario panamericano firmado por 18 países de las Américas
Emisión del código sanitario panamericano firmado por 18 países de las Américas -
Constitución de la Organización mundial de la salud (OMS)
-
Establecen un esquema para tratar de explicar el desarrollo natural de las enfermedades
-
 Se crea el término de VACUNA por observaciones y experimentaciones
Se crea el término de VACUNA por observaciones y experimentaciones -
 Se creó el Centro de investigación en salud pública
Se creó el Centro de investigación en salud pública -
 Cambia de denominación a Centro de Investigación en Salud Pública
Cambia de denominación a Centro de Investigación en Salud Pública -
Se definen las funciones de la organización de salud pública
-
 Lanzamiento de iniciativa de lucha contra el sarampión
Lanzamiento de iniciativa de lucha contra el sarampión -
 Se creó el fondo mundial de lucha contra el SIDA y tuberculosis
Se creó el fondo mundial de lucha contra el SIDA y tuberculosis -
 La asamblea mundial de la salud aprobó renovar el convenio para el control del tabaco, el más apoyado en la historia de las naciones unidas.
La asamblea mundial de la salud aprobó renovar el convenio para el control del tabaco, el más apoyado en la historia de las naciones unidas. -
 Se dio origen al sistema de protección social en salud (SPSS)
Se dio origen al sistema de protección social en salud (SPSS) -
Asamblea mundial de la salud aprobó renovar el estado de salud de las personas con atención primaria
-
La agencia Europea de medicamentos aprueba la primera terapia genética para una enfermedad hereditaria
-
 Brotes de fiebre amarilla en las Américas
Brotes de fiebre amarilla en las Américas -
 OMS declara pandemia mundial por los alarmantes niveles de propagación de covid-19
OMS declara pandemia mundial por los alarmantes niveles de propagación de covid-19
Plan projects on a visual timeline
Map milestones, phases, deadlines, and key events in one place so the sequence is easier to see and share. Timetoast is a timeline maker for work, school, research, and stories.